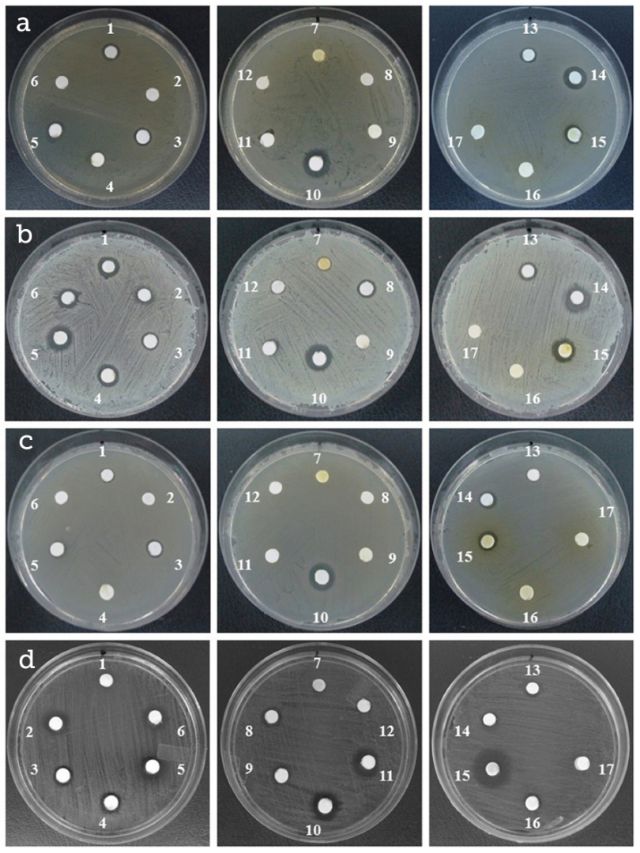
Figure 1

Antimicrobial evaluation of plant essential oils against pathogenic microorganisms: In vitro study of oregano oil combined with conventional food preservatives
Evaluación antimicrobiana de aceites esenciales de plantas contra microorganismos patógenos: Estudio in vitro del aceite de orégano combinado con conservadores alimenticios convencionales
Antimicrobial evaluation of plant essential oils against pathogenic microorganisms: In vitro study of oregano oil combined with conventional food preservatives
Acta Universitaria, vol. 28, no. 4, pp. 10-18, 2018
Universidad de Guanajuato
Received: 02 March 2017
Accepted: 01 February 2018
Published: 01 October 2018
Abstract: Essential oils (EO) are promising natural antimicrobial additives to control microbial pathogens. This study aims to investigate the antimicrobial activities of plant essential oils and to study the antimicrobial effect of oregano oil (OrO) in combination with food preservatives. The antimicrobial screening showed that Escherichia coli and Salmonella enterica subsp. enterica serovar Typhimurium (Salmonella ser. Typhimurium) appeared to be less susceptible to EO, whereas Staphylococcus aureus and Candida albicans were more affected. The Minimum Inhibitory Concentration (MIC) and Minimum Lethal Concentration (MLC) for laurel, cumin, oregano and rosemary oils showed values ranging from 0.078% to 1.25% (v/v). Also, synergic and viability effects of OrO combined with acetic acid (AcA) showed an additive effect against E. coli and C. albicans, while combination OrO + ascorbic acid (Asc) exhibited the same effect over Salmonella ser. Typhimurium and C. albicans. Therefore, oregano oil in combination with preservatives could be used to control the growth of pathogenic microorganisms for food preservation.
Keywords: Essential oil, oregano, ascorbic acid, synergy, lethal curves.
Resumen: Los aceites esenciales (EO) son aditivos antimicrobianos naturales para el control de microorganismos patógenos. El objetivo del estudio fue investigar la actividad antimicrobiana de aceites esenciales de plantas y el efecto antimicrobiano del aceite de orégano (OrO) combinado con conservadores alimenticios. Las actividades antimicrobianas con los EO mostraron a Escherichia coli y Salmonella enterica subsp. enterica serovar Typhimurium (Salmonella ser. Typhimurium) menos susceptibles que Staphylococcus aureus y Candida albicans. La Concentración Mínima Inhibitoria (MIC, por sus siglas en inglés) y la Concentración Mínima Letal (MLC, por sus siglas en inglés) para los aceites de laurel, comino, orégano y romero fluctuaron entre 0.078% a 1.25% (v/v). Además, el OrO combinado con ácido acético (AcA) tuvo un afecto aditivo contra E. coli y C. albicans, mientras que la combinación OrO con ácido ascórbico (Asc) tuvo el mismo efecto sobre Salmonella ser. Typhimurium y C. albicans. Por tanto, el aceite de orégano combinado con conservadores podría ser empleado para controlar el crecimiento de microorganismos patógenos preservando los alimentos. INTRODUCTION
Palabras clave: Aceite esencial, orégano, ácido ascórbico, sinergia, curva de letalidad.
INTRODUCTION
Essential oils (EO) are an interesting group of substances obtained from plant material; almost exclusively from flowers, leaves, barks, woods, roots, rhizomes, fruits and seeds (Burt, 2004; Celiktas et al., 2006). Generally, EO are liquids although they exhibit an oily consistency with an aromatic and pleasant odor (Bassolé & Juliani, 2012). Chemically, EO are a complex and highly variable mixture of constituents appertaining to different groups such as terpenes and aliphatic compounds with antibacterial and antifungal properties (Carmo, de Oliveira Lima & de Souza, 2008; Delamare, Moschen-Pistorello, Artico, Atti-Serafini & Echeverrigaray, 2007; Pichersky, Noel & Dudareva, 2006).
Food safety represents a major problem, especially in the low-income countries, which affects hundreds of millions of people as a consequence of the increment in the incidence of food-borne diseases. With the purpose of achieving an accurate shelf life, a great number of food products require protection against spoilage during the stages of: i) preparation, ii) storage and iii) distribution (World Health Organization [WHO], 2007). Another major problem is due to the ability of microorganisms to survive in food, causing spoilage and quality deterioration (Jacob, Mathiasen & Powell, 2010). The development of food preservation methods arises from the necessity of extending the shelf life and improves the storage conditions. Alternative methods to synthetic chemical preservatives include non-thermal inactivation technologies: radiation, high pressure, pulsed electric fields, modified atmosphere, biopreservation and antimicrobial compounds derived from plants (Devlieghere, Vermeiren & Debevere, 2004).
The food and pharmaceutical industries have shown great interest towards antimicrobial properties of EO, since the use of natural additives seems to be effective for replacing synthetic preservatives (Das, Tiwari & Shrivastava, 2010). Frequently, these natural compounds are in demand because they are eco-friendly, degradable, free of side effects and cheaper than chemical preservatives. Nevertheless, it has been assessed that EO antimicrobial activity derived from plants of the same species could be extremely different. These differences could be related to geographical growing regions, harvest time, genotype and weather conditions. For this reason, EO biological activity obtained from plants, grown in a determined region, requires characterization (Oussalah, Caillet, Saucier & Lacroix, 2007). Oregano has been found to possess antimicrobial activity, which may have beneficial applications in food. However, a major effect of the oil use in food is related to the sensorial modification of taste. A number of studies have focused on the synergistic activity of EO combinations in order to reduce the negative sensory impact and to obtain an effective antimicrobial activity (Fu et al., 2006; Gutierrez, Barry-Ryan & Bourke, 2009). Other researchers are mainly focused on EO synergic effect in combination with other natural antibacterial compounds (Solomakos, Govaris, Koidis & Botsoglou, 2008). The combination oregano-ascorbic acid has been used to avoid deterioration of meat quality and as diet supplement, but its effect on microbial growth has not been explored (Ghazi, Amiadian & Norouzi, 2015; Young, Stagsted, Jensen, Karlsson & Henckel, 2003). Therefore, the present study deals with the evaluation of certain commercial EO and chemical preservatives against pathogenic microorganisms. The primary aim of this work is to evaluate the synergic and viability effects of oregano oil in combination with ascorbic acid.
MATERIALS AND METHODS
Source of essential oils
Fourteen commercial EO including laurel (91028), onion (10005), Mexican lemon 1 (91027), Mexican lemon 2 (91031), cumin (91018), black pepper (91048), orange 5VC (91155), ginger (91026), sweet orange (91041), commercial oregano 296 (10053), garlic (10000), grapefruit (91064), lemon (10009) and rosemary (91053) were purchased by Aceites-Essencefleur, Flavor’s Division (http://www.essencefleur.com).
Microbial inocula
Escherichia coli ATCC 25922, Salmonella enterica subsp. enterica serovar Typhimurium ATCC 14028, and Staphylococcus aureus ATCC 25923 were obtained from the American Type Culture Collection (ATCC). Candida albicans was supplied by the National Culture Collection, CINVESTAV-IPN, México. Bacterial cultures were maintained at 4 °C on Nutrient Agar (NA) and yeast on Sabouraud Dextrose Agar slants (SDA). Bacterial inocula were prepared on Mueller-Hinton (MH) broth in order to achieve 1 × 106 CFUml-1. For yeast, the inoculum was prepared by diluting an overnight culture with Sabouraud Dextrose broth until it reached 1 × 106 CFUml-1 (Oliva et al., 2010).
Antimicrobial screening of EO by disc diffusion method
A preliminary screening to select EO with antimicrobial activities was accomplished by Disc Diffusion Method (Carović-Stanko et al., 2010). The adequate solidified media (MH agar for bacterial strains and SDA for C. albicans) were seeded with 0.1 ml of inoculum suspension at 106 CFUml 15 mm zone of inhibition was strongly inhibitory; 10 mm - 15 mm zone of inhibition was moderately inhibitory, and < 10 mm was not inhibitory (figure 1).
Antimicrobial screening of plant essential oils against microbial pathogens by the disc diffusion method. Panel A, Escherichia coli; panel B, Staphylococcus aureus; panel C Salmonella ser. Typhimurium; panel D, Candida albicans. Oils: 1, laurel; 2, onion; 3, mexican lemon 1; 4, mexican lemon 2; 5, cumin; 6, black pepper; 7, orange SVC; 8, ginger; 9, sweet orange; 10, commercial oregano; 11, garlic; 12, grapefruit; 13, lemon; 14, rosemary; 15, concentrated phenol citric extract I; 16, concentrated phenol citric extract II; 17, concentrated phenol citric extract III.
Source: Author's own elaboration.A modified disc-diffusion method to evaluate selected essential oils was implemented. Briefly, EO solutions were diluted in 100% Dimethyl sulfoxide (DMSO) at concentrations ranges of 3 μgml-1, 5 μgml-1, 7 μgml-1, and 10 μgml-1. DMSO, a non-toxic dispersing solvent was used to increase diffusion of oils onto the agar Petri plates. Solutions were kept in amber glass vials at ± 4 °C as stock solution. Sterile paper discs were soaked with 10 μL of diluted oils and placed on the inoculated media with the corresponding microorganisms, as described previously. Paper disc moistened w ith 10 μl of 100% DMSO was used as negative control. The Petri plates were incubated, and diameters of the inhibition were measured as mentioned above. Kanamycin and itraconazole were positive controls for bacteria and yeast, respectively (data not shown; stock solutions at 200μgml-1 and 500 μgml-1, respectively). The assays were carried out in triplicate.
Inhibitory and lethal concentrations of EO and food preservatives by micro-dilution test
The Minimum Inhibitory Concentrations (MIC) and Minimum Lethal Concentrations (MLC) tests were accomplished by micro-dilution method using 96-well microtitre plates. Solutions of 5% (v/v) EO (oregano, laurel, cumin and rosemary) were prepared with DMSO. The 96-well plates were arranged dispersing 100 μl of 2 X MH broth for bacteria or 2X SDB for yeast; afterwards, 100 μl of EO solution was added to the first wells and two-fold serial dilutions were performed to obtain a concentration range from 0.1% to 1.25% (v/v). In addition, 100 μl of the bacteria or yeast inocula were added to the wells and mixed, and microplates were incubated at adequate temperatures for 24 h or 48 h. The MIC were determined after adding 10 μl per well of 20 mgml-1 TTC (2, 3, 5-Triphenyltetrazolium chloride, Sigma-Aldrich) incubated under the appropriate conditions for at least 3 h in darkness (Sartoratto et al., 2004). The MLC was determined by serial sub-cultivations of 2 μl from MIC wells in micro plates containing 100 μl of broth + 10 μl of 20 mgml-1 TTC per well. Micro plates were further incubated for 24 h. The lowest concentration showing no visible colour was defined as the MLC, indicating 99.5% of the original inocula killing. The study determined the MIC and MLC concentrations of conventional preservatives used in food products. Stock solutions showed the following values: 3% (w/v) sodium benzoate, 8% (w/v) ascorbic acid (Asc), commercial vinegar, and 12% (v/v) acetic acid (AcA). Finally, MIC and MLC values of the combination of OrO with AcA or Asc to inhibit the microbial growth was evaluated by the 96-well micro-dilution method, as mentioned above. In order to obtain the combinations, MIC obtained from the individual test were used to mix the compounds in a range of concentrations from 2% to 0.125%. MIC and MLC values were obtained from two independent experiments with two replicates.
Checkerboard test and time-kill curves
Checkerboard experiments and time-kill curves were performed using 96-well microtiter plates with the purpose of evaluating and quantifying the antimicrobial activity of oregano oil and their combinations with acetic acid and ascorbic acid (Marchetti, Moreillon, Glauser, Bille & Sanglard, 2000).
a) Checkerboard microtiter plate testing. The micro plates were arranged distributing 50 μl 2 X MH broth for bacteria or 2X SDB yeast into each well. After this, 50 μl of oregano oil was twofold diluted along the x-axis, and 50 μl of AcA or Asc were two-fold diluted along the y-axis to give a final volume in each well of 100 μl. An equal volume of cells suspension containing 106 CFUml-1 of the tested microorganism was added to each well. Then, the plates were incubated at 37 °C for 24 h or 29 °C for 48 h under aerobic conditions. The Fractional Inhibitory Concentration Index (FICI) was calculated as follows: FICI = FICA + FICB; where: FICA = MIC of OrO in combination with AcA or Asc/MIC of OrO alone (MIC-AB/MIC-A), and FICB = MIC of AcA or Asc in combination with OrO/MIC of AcA or Asc alone (MIC-BA/MIC-B).
The results were interpreted as follows: synergy (FICI <0.5), addition (FICI >0.5 and ≤1.0), indifference (FICI >1.0 and ≤4.0) or antagonism (FICI >4.0).
b) Time-kill assays. For bacteria, a loopful of cells from a single colony grown on MH agar Petri plates was transferred to an Erlenmeyer flask with 50 ml of MH broth. These cultures were maintained at 37 °C/ 150 rpm until the OD600 reached 0.5-0.6. Afterwards, 25 ml of the culture were transferred to an Erlenmeyer flask and mixed with solutions of Asc, OrO and the combination OrO + Asc equivalent to ½ MIC (0.25%), 2 MIC (0.16%) and ½ + 2 MIC (0.25% + 0.16%), respectively. The optical density was registered at predetermined time points (0, 2, 4, 6, 8 and 24). The effect of each treatment regarding the cell viability was assessed by sub-culturing 10 μl of each culture, into a 24-well plate containing 2 ml of MH medium (per well) and TTC (final concentration of 0.001%). Micro plates were incubated at 37 °C for 24 h and it was possible to record a visible color. Each experiment included growth control in the absence of ascorbic acid or essential oil. Assays were conducted in triplicate. Time-kill curves were constructed by plotting optical density against time (h). Experiments for C. albicans were conducted in the same way, except that culture medium was SDA and SD-broth (at 29 °C).
Statistical Analysis
The data related to inhibition by the disc diffusion assays were expressed as mean ± standard deviation (SD). Means were compared using an Analysis of Variance (Anova) followed by LSD testing at p = 0.05. Statistical analysis was performed through Stat Graphics Centurion version XV V16.2.04 (Stat point Technologies, Inc).
RESULTS AND DISCUSSION
Selection of plant essential oils with antimicrobial activity
This study evaluated the in vitro antimicrobial activity of several commercial essential oils from aromatic plants and four preservatives usually employed in food industries. Table 1 summarizes the antimicrobial activity of the EO against pathogenic microorganisms. It is observed that laurel, cumin, oregano, and rosemary oils exhibited inhibitory activity against the four pathogens tested. S. aureus, E. coli and Salmonella ser. Typhimurium were susceptible to 7, 6 and 5 EO, respectively, while C. albicans was the most sensitive pathogen to plant oils. Also, it is shown that OrO exhibited the highest inhibition diameter zone. The statistical analysis confirmed the above results (p = 0.05). Several studies have shown inhibitory effects of EO on Gram positive and Gram negative bacteria. Lemon, orange and rosemary EO inhibited the growth of S. aureus and E. coli, while oregano demonstrated to be extremely active against E. coli O157:H7, S. aureus and Salmonella ser. Typhimurium (Di Pasqua, De Feo, Villani & Mauriello, 2005; Elgayyar, Draughon, Golden & Mount, 2001; Prabuseenivasan, Jayakumar & Ignacimuthu, 2006). Other studies demonstrated significant inhibitory activity on Fluconazole-resistant Candida species (Rabadia, Kamat & Kamat D., 2001). In this study, the most susceptible pathogen to the EO was S. aureus as indicated in other works (Delaquis, Stanich, Girard & Mazza, 2002).

† Different letters are significantly different (p = 0.05). Zero, no inhibition. ND, not determined. No inhibitory effect on microorganisms’ growth were detected with 100% DMSO.
Source: Author's own elaboration.To avoid the irregular distribution of oils into the culture medium derived from their water insolubility, hydrophobic nature and high viscosity, a dispersant agent as solubilizing agent was selected. DMSO was used to prepare laurel, cumin, oregano and rosemary solutions at concentrations from 3 mgml-1 to 10 mgml-1. Table 2 showed that oregano exerted the highest inhibitory effect with an inhibition diameter of more than 16 mm on E. coli, Salmonella ser. Typhimurium and C. albicans. In turn, rosemary oil inhibited E. coli and S. aureus cells in the same proportion. The study confirms that S aureus is the most susceptible microorganism regarding EO. These results showed that DMSO improve the activity of oils in water based-media increasing their inhibitory activity.

* Mean of three replicates (± SD). Statistical differences were calculated for each microorganism, wherein means in columns followed by different letters are significantly different (p < 0.05). No inhibitory activity was detected with paper disc soaked with 100% DMSO.
Source: Author's own elaboration.Determination of MIC and MLC values for the inhibition of microbial pathogens
The MIC and MLC values of laurel, cumin, oregano, and rosemary EO were calculated considering their inhibitory activity against the pathogens (table 3). Additionally, MIC and MLC concentrations for some food preservatives were also obtained. Based on the metabolic activity on TTC, the MIC showed the lowest concentration where no visible microbial growth was detected, and the MLC showed the lowest concentration of an antimicrobial agent to be lethal to a particular microbe. The analysis demonstrated that the most efficient inhibitory oil against the pathogenic microorganisms was oregano with a MIC value of 0.078% (v/v), followed by cumin (0.313%, v/v), and rosemary (0.313% to 0.625%, (v/v). In accordance to this, the MLC of EO was extremely close to the MIC, indicating a good lethal activity against the pathogens tested. A previous study showed a strong antibacterial activity for oregano and rosemary on E. coli and S. aureus at concentrations of about 0.125% to 5% (w/v), while cumin needed higher concentrations to exert antimicrobial effects (> 4%, w/v) (Witkowska, Hickey, Alonso-Gomez & Wilkinson, 2013). Oregano oil presented similar MIC-MLC values (0.5-1.0% v/v) against S. aureus, Salmonella ser. Typhimurium, and E. coli, according to previous studies (Soković, Marin, Brkić & Van Griensven, 2007). Variations to antimicrobial activities detected in the EO could be attributed to the different chemical composition as a consequence to the existence of a diversity of conditions attributable to plant subspecies, different agro-climatic conditions for plant breeding, plant maturity stage, and particular distillation conditions to obtain the oils (Anwar, Hussain, Sherazi & Bhanger, 2009).

† Concentration in% (v/v for EO, vinegar and acetic acid; w/v for sodium benzoate and ascorbic acid). (-) No inhibitory or lethal effect. No inhibitory effect on microorganisms’ growth were detected with 100% DMSO.
Source: Author's own elaboration.The mechanism of antibiosis of the extracts was calculated using the ratio of MLC/MIC (Okeleye, Mkwetshana & Ndip, 2013). An index ratio of ≤ 2 observed for oregano, cumin, laurel, and rosemary suggested a bactericidal/fungicidal mechanism to inhibit the growth of the pathogens evaluated (table 4). The only exception was obtained for cumin on S. Typhimurium with an activity ratio of 4.0.

† Results are means of three different experiments. ¥ The results were interpreted as: synergistic (S, FICI < 0.5), additive (A, FICI > 0.5 and ≤ 1.0), indifferent (I, FICI > 1 and ≤ 4), or antagonistic (AN, FICI > 4).
Source: Author's own elaboration.In relation with the antimicrobial evaluations for common food preservatives, the MIC values obtained for Asc ranged from 0.5% to 1%, lower in comparison to the results reported by Zhang, Wakisaka, Maeda & Yamamoto (1997); e.g. a higher concentration of ascorbic acid was required to inhibit E. coli growth (> 1.6% w/v). Commercial vinegar was effective against all microorganisms in concentrations ranging from 0.313% to 1.25% (v/v), but C. albicans was the most resistant pathogen. A previous study presented similar results wherein the MIC value of 0.1% to 0.2% (v/v) was effective against S. aureus, S. epidermidis, Proteus vulgaris, Pseudomonas aeruginosa and E. coli (Lang, 2013). Sodium benzoate preservative exerted a bacteriostatic activity against E. coli and Salmonella ser. Typhimurium and bactericidal over S. aureus; C. albicans was not affected by the compound. It is worth mentioning that in previous works a strong anticandidal activity at a concentration of 0.25% (2.5 mg/ml) was obtained (Stanojevic, Comic, Stefanovic & Solujic-Sukdolak, 2009).
It was found that AcA showed the lowest MIC value (0.1%) in relation to the other preservatives with concentrations previously reported (Pundir & Jain, 2011).
Synergic and viability evaluation of the combinations of oregano oil and conventional preservatives
Previous results showed that EO present high efficiency against the tested pathogens, particularly in the case of oregano oil. Notwithstanding, a higher concentration of essential oil is required to achieve the same effect in food (Burt, 2004). This action can alter the organoleptic properties of food, modifying the food taste or exceed the acceptable flavor thresholds (Hsieh, Mau & Huang, 2001). Combinations of plant essential oils can help to reduce the concentrations and, as a consequence, to reduce the sensory impact. In the light of the foregoing, the current research was extended to evaluate the effect of OrO in combination with Asc and AcA to inhibit the microbial growth. Table 4 shows that OrO presents greater efficacy in combination with acidificants; MIC and MLC values were dropped by a half, being more efficient with AcA.
The quantitative effects of oregano in combination with acidic preservatives (AcA or Asc) were determined by the checkerboard test in terms of FIC indexes (FICI). Results show that none of these combinations demonstrated synergistic activity against E. coli, Salmonella ser. Typhimurium, S. aureus, and C. albicans (table 4). The OrO + AcA combination showed an additive effect on E. coli and C. albicans, but it was indifferent against Salmonella ser. Typhimurium and S. aureus. In contrast, the OrO + Asc combination exhibited an additive effect over Salmonella ser. Typhimurium and C. albicans, and indifferent for E. coli and S. aureus. No antagonistic activity was observed between the combinations evaluated. MIC values for these combinations resulted in the following way: OrO + AcA at 0.313%-0.1%-0.2% for S. aureus, E. coli and C. albicans and 0.078%-0.2% for Salmonella ser. Typhimurium; OrO-Asc at 0.078%-0.25% for Salmonella ser. Typhimurium, 0.156%-0.25% for C. albicans, 0.313%-0.5% for S. aureus, and 0.625%-1% for E. coli.
In agreement with the notion that any food preservative or additive should not alter or modify the food taste, oregano oil combined with ascorbic acid was selected as a mixture to evaluate the effect on microbial viability by time-kill curves. Previously, an assay was implemented with MIC values at 1X of Asc; 4X of OrO and 4X-1X of the combination OrO-Asc. Results demonstrated a strong inhibitory effect of Asc and OrO over microbial growth 2 h after the beginning of the assay, suggesting that a lower concentration should be assessed in order to implement the kill curves (data not shown). Figure 2 presents viability effects towards the four microorganisms. In the case of E. coli and Salmonella ser. Typhimurium, the checkerboard test results regarding the indifferent and additive synergistic activity of the OrO-Asc combination were confirmed (figure 2a, 2b, respectively). In contrast to the checkerboard results, S aureus and C. albicans kill curves exhibited different effects on growth in relation to the OrO-Asc combination. In S aureus, it was possible to observe certain additive activity linked to growth; on the other hand, in C. albicans, an indifferent effect on growth was detected (figure 2c, 2d). In addition to this, kill curves demonstrated that Asc exerted bacteriostatic or fungistatic activity, because E. coli, Salmonella ser. Typhimurium and S. aureus growth was restored 4 h and 8 h after Asc addition. For instance, in Salmonella ser. Typhimurium, it was possible to observe growth reduction after 2 h of exposure to Asc, OrO and Oro-Asc. However, cells that were grown in culture media containing Asc were able to maintain viability throughout the experiment. This does not apply in the case of cells cultured with OrO or OrO-Asc which died in less than a couple of hours (figure 3).

Effect of oregano oil ascorbic acid (□, ASC), oregano oil ▲, OR) and the combination (⚫, OR:ASC) against Escherichia coli (a), Salmonella ser. Typhimurium (b), Staphylococcus aureus (c) and Candida albicans (d). Each point represents the mean of triplicate determinations.
Source: Author's own elaboration.

The effect of treatments on Salmonella ser. Typhimurium cells viability during the first 8 hours of the time-kill curve. Line 1, M-H culture media; line 2, M-H media supplemented with ASC; line 3, M-H media plus OR; line 4, M-H media added with the combination OR:ASC. * M-H media non-inoculated.
Source: Author's own elaboration.Foremost, EO biological activity is attributed to two major chemical groups of low molecular weight, which include aromatic and aliphatic constituents (Bassolé & Juliani, 2012). A large amount of their antimicrobial properties seems to derive from oxygenated terpenoids; particularly phenolic terpenes, phenylpropanoids, and alcohols. The lipophilic characteristic of oils allows a simple diffusion through the microbial cell wall and cytoplasmic membrane.
Moreover, the cytotoxic activity appears to be linked to the structure disruption of polysaccharide, fatty acid and phospholipid layers, due to a multi–target hitting mechanism (Betoni, Mantovani, Barbosa, Di Stasi & Fernandes, 2006). An increasing number of studies have reported the microbial inhibitory effect of ascorbic acid alone or in combination with other compounds (Kallio, Jaakkola, Mäkil, Kilpeläinen & Virtanen, 2012). Other studies have demonstrated that synergism between ascorbic acid and phenolic compounds is due to the ascorbic acid ability to prevent the phenolic compounds oxidation (Hatano et al., 2008).
A great number of recent studies support the use of essential oils as natural food preservers that could be directly used in food products or in food cleaning products. As a result, researchers have been testing the antimicrobial action of a huge variety of safer essential oils. This behavior is a forceful reason to show interest in synergistic compounds that could be used to increase the antimicrobial activity of essential oils (Zanbuchini, Fiorini, Verdenelli, Orpianesi & Ballini, 2008).
CONCLUSIONS
Natural plant oils represent potential additives that may be employed to prevent bacterial and fungal growth in foods and replace the use of synthetic chemical preservatives. On the basis of the results of the study, we can conclude that oregano, cumin, laurel, and rosemary essential oils present antimicrobial activity against E. coli, Salmonella ser. Typhimurium, S. aureus, and C. albicans. The combination of oregano oil and ascorbic acid could be adequate for use as food preservatives and provide essential protection against food-borne contamination without altering the taste, appearance and other characteristics of processed or prepared foods. Furthermore, the addition of ascorbic acid may be an alternative to increase the antimicrobial activity through the inhibition of phenolic compounds oxidation.
Acknowledgements
This study was supported by Fondos mixtos FOMIX Conacyt-Yucatán (YUC-2011-C09-172091). To Dr. Diana K. Baigts Allende for the critical review, comments, and English editing on the manuscript.
References
Anwar, F., Hussain, A. I., Sherazi, S. T. H., & Bhanger, M. I. (2009). Changes in composition and antioxidant and antimicrobial activities of essential oil of fennel (Foeniculum vulgare Mill.) fruit at different stages of maturity. Journal of Herbs, Spices & Medicinal Plants, 15(2), 1-16. doi: 10.1080/10496470903139488
Bassolé, I. H. N., & Juliani, H. R. (2012). Essential oils in combination and their antimicrobial properties. Molecules, 17(4), 3989-4006. doi:10.3390/molecules17043989
Betoni, J. E. C., Mantovani, R., Barbosa, L., Di Stasi, L. C., & Fernandes, A. (2006). Synergism between plant extract and antimicrobial drugs used on Staphylococcus aureus diseases. Memórias do Instituto Oswaldo Cruz, 101(4), 387-390. doi: 10.1590/S0074-02762006000400007
Burt, S. (2004). Essential oils: their antibacterial properties and potential applications in foods. a review. International Journal of Food Microbiology, 94(3), 223-253. doi: 10.1016/j.ijfoodmicro.2004.03.022.
Carmo, E., de Oliveira, E., & de Souza, E. (2008). The potential of Origanum vulgare L. (Lamiaceae) essential oil in inhibiting the growth of some food-related Aspergillus species. Brazilian Journal of Microbiology, 39(2), 362-367. doi: 10.1590/S1517-83822008000200030.
Carović-Stanko, K., Orlić, S., Politeo, O., Strikić, F., Kolak, I., Milos, M., & Satovic, Z. (2010). Composition and antibacterial activities of essential oils of seven Ocimum taxa. Food Chemistry, 119(1), 196-201. doi: 10.1016/j.foodchem.2009.06.010.
Celiktas, O. Y., Kocabas, E., Bedir, E., Sukan, F. V., Ozek, T., & Baser, K. H. C. (2006). Antimicrobial activities of methanol extracts and essential oils of Rosmarinus officinalis, depending on location and seasonal variations. Food Chemistry, 100(2), 553-559. doi: 10.1016/j.foodchem.2005.10.011.
Das, K., Tiwari, R. K. S., & Shrivastava, D. K. (2010). Techniques for evaluation of medicinal plant products as antimicrobial agents: current methods and future trends. Journal of Medicinal Plants Research, 4(2), 104-111.
Delamare, A. P., Moschen-Pistorello, I. T., Artico, L., Atti-Serafini, L., & Echeverrigaray, S. (2007). Antibacterial activity of the essential oils of Salvia officinalis L. and Salvia triloba L. cultivated in South Brazil. Food Chemistry, 100(2), 603-608. doi: 10.1016/j.foodchem.2005.09.078.
Delaquis, P. J., Stanich, K., Girard, B., & Mazza, G. (2002). Antimicrobial activity of individual and mixed fractions of dill, cilantro, coriander and eucalyptus essential oils. International Journal of Food Microbiology, 74(1-2), 101-109. doi: 10.1016/j.foodchem.2005.09.078.
Devlieghere, F., Vermeiren, L., & Debevere, J. (2004). New preservation technologies: Possibilities and limitations. International Dairy Journal, 14(4), 273-285. doi: 10.1016/j.idairyj.2003.07.002.
Di Pasqua, R., De Feo, V., Villani, F., & Mauriello, G. (2005). In vitro antimicrobial activity of essential oils from Mediterranean Apiaceae, Verbenaceae and Lamiaceae against foodborne pathogens and spoilage bacteria. Annals of Microbiology, 55(2), 139-143.
Elgayyar, M., Draughon, F. A., Golden, D. A., & Mount, J. R. (2001). Antimicrobial activity of essential oils from plants against selected pathogenic and saprophytic microorganisms. Journal of Food Protection, 64(7), 1019-1024. doi: 10.4315/0362-028X-64.7.1019
Fu, Y. J., Zu, Y. G., Chen, L. Y., Shi, X. G., Wang, Z., Sun, S., & Efferth, T. (2006). Antimicrobial activity of clove and rosemary essential oils alone and in combination. Phytotherapy Research, 21(10), 989-994. doi: 10.1002/ptr.2179.
Ghazi, S., Amiadian, T., & Norouzi, S. (2015). Single and combined effects of vitamin C and oregano essential oil in diet, on growth performance, and blood parameters of broiler chicks reared under heat stress condition. International Journal of Biometeorology, 59(8), 1019-1024. doi: 10.1007/s00484-014-0915-4.
Gutierrez, J., Barry-Ryan, C., & Bourke, P. (2009). The antimicrobial efficacy of plant essential oil combinations and interactions with food ingredients. International Journal of Food Microbiology, 124(1), 91-97. doi: 10.1016/j.ijfoodmicro.2008.02.028.
Hatano, T., Tsugawa, M., Kusuda, M., Taniguchi, S., Yoshida, T., Shiota, S., & Tsuchiya, T. (2008). Enhancement of antibacterial effects of epigallocatechin gallate, using ascorbic acid. Phytochemistry, 69(18), 3111-3116. doi: 10.1016/j.phytochem.2007.08.013.
Hsieh, P. C., Mau, J. L., & Huang, S. H. (2001). Antimicrobial effect of various combinations of plant estracts. Food Microbiology, 18(1), 35-43. doi: 10.1006/fmic.2000.0376.
Jacob, C., Mathiasen, L., & Powell, D. (2010). Designing effective messages for microbial food safety hazards. Food Control, 21(1), 1-6. doi: 10.1016/j.foodcont.2009.04.011.
Kallio, J., Jaakkola, M., Mäkil, M., Kilpeläinen, P., & Virtanen, V. (2012). Vitamin C Inhibits Staphylococcus aureus growth and enhances the inhibitory effect of quercetin on growth of Escherichia coli in vitro. Planta Medica, 78(17), 1824-1830. doi: 10.1055/s-0032-1315388.
Lang, U. (2013). Minimal inhibitory concentration of natural vinegar and of aluminum acetate-tartrate solution. Otology & Neurotology, 34(5), 795-797. doi:10.1097/MAO.0b013e31829411d7.
Marchetti, O., Moreillon, P., Glauser, M. P., Bille, J., & Sanglard, D. (2000). Potent Synergism of the Combination of Fluconazole and Cyclosporine in Candida albicans. Antimicrobial Agents and Chemotherapy, 44(9), 2373-2381. Recuperado el 2 de febrero de 2017 de https://www.ncbi.nlm.nih.gov/pmc/articles/PMC90072/pdf/ac002373.pdf
Okeleye, B. I., Mkwetshana, N. T., & Ndip, R. N. (2013). Evaluation of the antibacterial and antifungal potential of Peltophorum africanum: toxicological effect on human Chang liver cell line. The Scientific World Journal, 2013, 1-9. doi: 10.1155/2013/878735.
Oliva, M. M., Beltramino, E., Gallucci, N., Casero, C., Zygadlo, J., & Demo, M. (2010). Antimicrobial activity of essential oils of Aloysia triphylla (L’Her.) Briton from different regions of Argentina. Boletín Latinoamericano y del Caribe de Plantas Medicinales y Aromáticas, 9(1), 29-37.
Oussalah, M., Caillet, S., Saucier, L., & Lacroix, M. (2007). Inhibitory effects of selected plant essential oils on the growth of four pathogenic bacteria: E. coli O157:H7, Salmonella Typhimurium, Staphylococcus aureus and Listeria monocytogenes. Food Control, 18(5), 414-420. doi: 10.1016/j.foodcont.2005.11.009.
Pichersky, E., Noel, J. P., & Dudareva, N. (2006). Biosynthesis of plant volatiles: Nature’s diversity and ingenuity. Science, 311(5762), 808-811. doi: 10.1126/science.1118510.
Prabuseenivasan, S., Jayakumar, M., & Ignacimuthu, S. (2006). In vitro antibacterial activity of some plant essential oils. BMC Complementary and Alternative Medicine, 6(39), 1-8. doi :10.1186/1472-6882-6-39.
Pundir, R. K., & Jain, P. (2011). Evaluation of five chemical food preservatives for their antibacterial activity against bacterial isolates from bakery products and mango pickles. Journal of Chemical and Pharmaceutical Research, 3(1), 24-31.
Rabadia, A. G., Kamat, S., & Kamat, D. (2011). Antifungal activity of essential oils against fluconazole resistant fungi. International Journal of Phytomedicine, 3(4), 506-510.
Sartoratto, A., Machado, A. L., Delarmelina, C., Figueira, G. M., Duarte, M. C., & Rehder, L. G. (2004). Composition and antimicrobial activity of essential oils from aromatic plants used in Brazil. Brazilian Journal of Microbiology, 35(4), 275-280. doi: 10.1590/S1517-83822004000300001.
Soković, M. D., Marin, P. D., Brkić, D., & Van Griensven, L. J. L. D. (2007). Chemical composition and antibacterial activity of essential oils of ten aromatic plants against human pathogenic bacteria. Food, 1(1), 220-226.
Solomakos, N., Govaris, A., Koidis, P., & Botsoglou, N. (2008). The antimicrobial effect of thyme essential oil, nisin and their combination against Escherichia coli O157:H7 in minced beef during refrigerated storage. Meat Science, 80(2), 159-166. doi: 10.1016/j.meatsci.2007.11.014.
Stanojevic, D., Comic, L., Stefanovic, O., & Solujic-Sukdolak, S. (2009). Antimicrobial effects of sodium benzoate, sodium nitrite and potassium sorbate and their synergistic action in vitro. Bulgarian Journal of Agricultural Science, 15(4), 307-311.
World Health Organization (WHO). (2007). Food safety and foodborne illness. World Health Organization, Geneva, Switzerland. Fact Sheet, 237, 1-4.
Witkowska, A., Hickey, D., Alonso-Gomez, M., & Wilkinson, M. (2013). Evaluation of antimicrobial activities of commercial herb and spice extracts against selected food-borne bacteria. Journal of Food Research, 2(4), 37-54. doi: 10.5539/jfr.v2n4p37.
Young, J. F., Stagsted, J., Jensen, S. K., Karlsson, A. H., & Henckel, P. (2003). Ascorbic acid, alpha-tocopherol, and oregano supplements reduce stress-induced deterioration of chicken meat quality. Poultry Science, 82(8), 1343-1351.
Zanbuchini, B., Fiorini, D., Verdenelli, M. C., Orpianesi, C., & Ballini, R. (2008). Inhibition of microbiological activity during sole (Solea solea L.) chilled storage by applying ellagic and ascorbic acids. LWT - Food Science and Technology, 41(9), 1733-1738. doi: 10.1016/j.lwt.2007.11.004.
Zhang, H. M., Wakisaka, N., Maeda, O., & Yamamoto, T. (1997). Vitamin C inhibits the growth of a bacterial risk factor for gastric carcinoma: Helicobacter pylori. Cancer, 80(10), 1897-1903. doi: 10.1002/(SICI)1097-0142(19971115)80:10<1897::AID-CNCR4>3.0.CO;2-L
Author notes
zevangelista@ciatej.mx
Additional information
Cómo citar: Evangelista-Martínez, Z., Reyes-Vázquez, N. & Rodríguez-Buenfil, I. (2018). Antimicrobial evaluation of plant essential oils against pathogenic microorganisms: In vitro study of oregano oil combined with conventional food preservatives. Acta Universitaria, 28(4), 10-18. doi: 10.15174/au.2018.1817